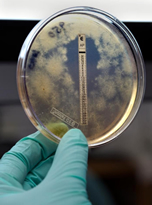

Read and report vaccine reactions, harassment and failures.
Haemophilus influenzae (H. influenzae) is a small gram-negative coccobacillus found only in humans and can be either encapsulated (typeable) or unencapsulated (nontypeable). Typeable H. influenzae contain a polysaccharide capsule and are identified and labeled with letters a through f. Strains that do not have a polysaccharide capsule are referred to as nontypeable. Current H. influenzae vaccines target only H. influenzae type b, which was believed to be the cause of 95 percent of all H. influenzae infections in the pre-vaccine era. Hib infections are more likely to occur between September and December and again between March and May.
H. influenzae type b (Hib) is transmitted by direct contact with respiratory secretions and enters the body through the upper respiratory tract. While uncommon, H. influenzae type b and other types of H. influenzae infections can also be transmitted through the birth canal from an infected mother to her newborn baby. In most cases, Hib can remain in the mouth and nose for up to several months without causing illness. If Hib enters the bloodstream it becomes invasive and cause serious infections including meningitis, pneumonia, bacteremia, epiglottis, cellulitis, septic arthritis, osteomyelitis, otitis media, pericarditis, and endocarditis.
A diagnosis of H. influenzae, including H. influenzae type b, is made by the laboratory testing of bodily fluids such as blood and spinal fluid.
Prior to the introduction of the Hib vaccine in the mid-1980’s, H. influenzae type b was responsible for most cases of meningitis, a serious infection of the membranes that cover the spinal cord and brain, which is the most common clinical presentation of invasive disease. Before Hib vaccines became available, infections occurred nearly exclusively in children under the age of five, with the majority of infections occurring in children younger than eighteen months. Of note, Navajo and Native Alaskan Americans were found to have higher rates of the disease. H.influenzae invasive disease did not become a nationally notifiable disease until 1991, six years after the first Hib vaccines became available for use in the United States.
Since the introduction of Hib vaccines, Hib meningitis has become more common in adults than in children. While the CDC reports a nearly 99 percent decrease in Hib invasive disease among children 5 years of age and younger, adults, especially seniors over the age of 65, have become more susceptible to the infection. A 2011 published study on H. influenzae infections in Utah found that between 1998 and 2008, over 50 percent of H. influenzae infections and 67 percent of H. influenzae related deaths occurred in adults over the age of 65.
In the United States, before Hib vaccines became available, approximately two-thirds of all cases of Hib invasive disease affected infants and children under 15 months of age and 85 percent of cases occurred in children under the age of five. Following the introduction of the Hib vaccine, the burden of invasive H. influenzae disease has shifted from children to adults, and most particularly seniors over the age of 65. A 2011 published study found that between 1998 and 2008, 51 percent of invasive H. influenzae cases involved adults over the age of 65. Death rates from H. influenzae disease were also found to be significantly higher among seniors over age 65, with 67 percent of infections resulting in death.
While invasive disease caused by H. influenzae type b (Hib) has decreased, invasive disease by non-b and nontypeable H. influenzae have increased. Non-b type infections, such as H. influenzae type a, can cause invasive disease with complications similar to Hib and nontypeable H. influenzae invasive illness, while most commonly associated with infections such as conjunctivitis, otitis media, sinusitis, and pneumonia, still has the potential to cause serious invasive H. influenzae disease. Hib vaccines target only H. influenzae type b and offers no protection against any other type of H. influenzae infection.
IMPORTANT NOTE: NVIC encourages you to become fully informed about Haemophilus Influenzae Type B (Hib) and the Hib vaccine by reading all sections in the Table of Contents, which contain many links and resources such as the manufacturer product information inserts, and to speak with one or more trusted health care professionals before making a vaccination decision for yourself or your child. This information is for educational purposes only and is not intended as medical advice.